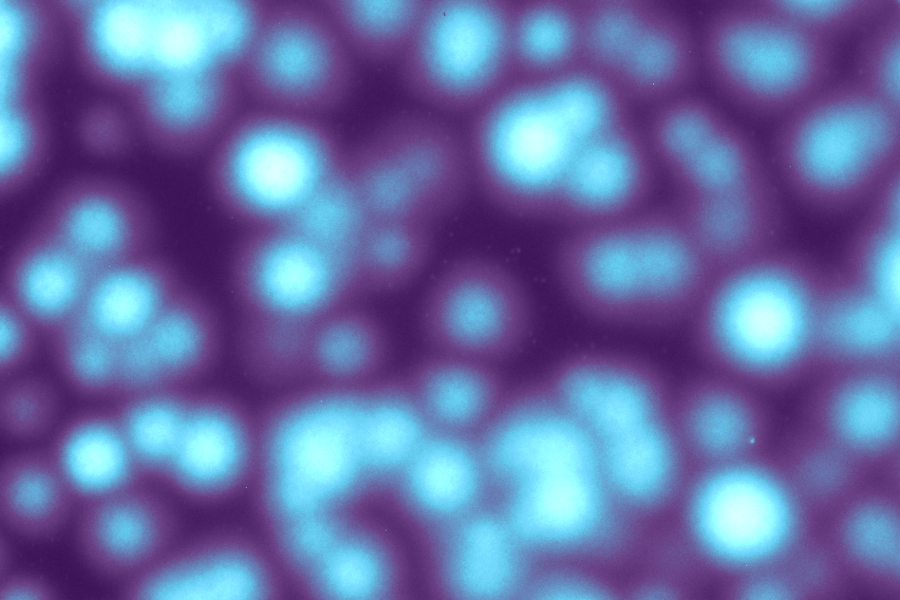

Natural systems such as grasslands form clusters, or patches, that bolster resilience under stress. Experiments show this same behavior can be modeled in bacteria with several important implications for creating survivable environments for threatened or endangered species, MIT researchers have reported online in Nature Microbiology.
Populations of the commonly studied soil bacteria Bacillus subtilis survive at much lower cell density when they form patches than when they are more evenly spread out in their environment, says Jeff Gore, the Latham Family Career Development Associate Professor of Physics. This patchy growth is sufficient by itself to enhance survival prospects, but it also reduces expansion.
In a resource-rich environment, mobility of the population is important because it leads to greater expansion, but in a resource-poor environment, keeping the population close together enables cooperative behavior to survive on sparse resources, Gore explains. These findings are relevant for conservation of more complex communities because they identify ways to enable population survival, in particular tailoring interventions to the environment.
The sugar hunt
B. subtilis, a gram positive bacteria, needs sugar in glucose form to survive. They can get this sugar either directly from their environment or by collectively producing the amylase enzyme, which breaks down starch in their environment into sugars that the bacteria can consume. Christoph Ratzke, a postdoc in the Physics of Living Systems Group at MIT, and lead author of the paper, “Self-organized patchiness facilitates survival in a cooperatively growing Bacillus subtilis population,” studied the bacteria under both conditions.
“He starts in a three-dimensional agar matrix where the cells are distributed uniformly. What he finds is if the population of cells is growing on a sugar like glucose that can be directly imported, then he sees that there is no patchiness. There is uniform growth throughout this three-dimensional volume,” Gore explains. “Whereas when he is growing these bacterial populations on starch where they’re growing collectively, then what he sees is the spontaneous self-organized emergence of patchy growth, where in some regions you get growth, in some regions, you don’t.”
Swimming doesn’t matter
In order to rule out other significant contributors to these patches forming, the researchers conducted the same tests with genetically defective bacteria that lacked the ability to sense the richer food source or that couldn’t swim. In the absence of swimming ability and sensing ability, patches still formed, the experiments showed.
The researchers also compared well-mixed environments where food and bacteria were evenly distributed by shaking to “spatial environments” where bacteria were allowed to spatially self-organize. Below the critical concentration, the bacteria die. Cell counts below the critical threshold for survival in a mixed environment were found to survive through clustering in the spatial environment. “There was a very big difference in terms of the density of the cells that were required for the survival. It required a much higher cell density in the well-mixed condition than in the spatial environment,” Gore explains.
Survival vs. expansion
In the experiments, the researchers were able to control bacterial movement in the agar growth medium by controlling the density of the agar. Results showed a tradeoff between survival and rate of population expansion. “If the population is starting at high cell density, then what is best for the population is to be in a high mobility regime, that is the low agar concentration, because then the population can expand very rapidly. However, if the population is at low cell density, it’s actually better to be in high agar concentrations with low mobility. That actually facilitates the formation of the patches,” Gore says.
“Because at higher agar concentration, where the bacteria are not able to swim as well, they can form very compact patches in which they can really grow cooperatively very well, and they can survive starting from very low cell density, but then once they have grown up, the patches are unable to expand very well just because they can’t swim very well,” he says.
“The most interesting aspect of this work is self-organized patch formation among cooperative cells, which was unexpected,” says Wenying Shou, who was not involved in the research. “The formation of these patches was driven by cell heterogeneity, local cooperation, and global inhibition, thus making these patterns Turing patterns.” Shou, who studies evolution of cooperation and microbial communities at the Fred Hutchinson Cancer Research Center in Seattle, notes that disease-causing bacteria that are known to engage in cooperation also could enhance their survival by using spontaneous patch formation.
Cheater vs. cooperators
Gore’s prior work examined the competition between cheaters and cooperators in budding yeast that secrete an enzyme that breaks down sucrose, a smaller and less complicated molecule than starch. The cooperators contribute to the public good by secreting the enzyme, whereas the cheaters don’t contribute to the public good and instead simply consume the glucose created by the cooperators.
“What we found is that a cheater strain could spread in the population, but that we got coexistence between the producers and the non-producers, between the cooperators and the cheaters,” Gore explains.
Ratzke next will focus on similar studies of producers and non-producers in B. subtilis bacteria. “Similar dynamics could take place even between species,” Gore says. “You could have this B. subtilis species interacting with another species that doesn’t produce amylase, and they may have similar dynamics. This is pointing to some potentially, I think, really deep similarities between evolution and ecology. That you could have evolution within a species, or you could have ecological dynamics between species, and you could get rather similar phenomena.”